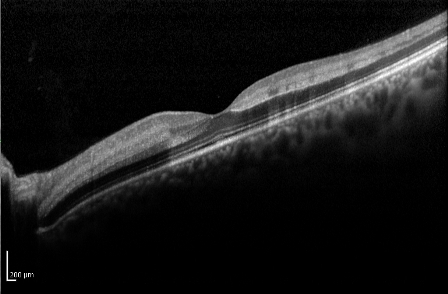
Edema OCT.jpg
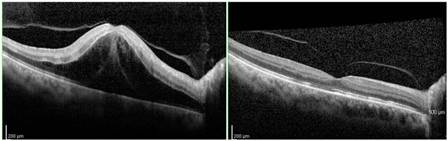
Edema.jpg

Central Retinal Vein Occlusion
All content on Eyewiki is protected by copyright law and the Terms of Service. This content may not be reproduced, copied, or put into any artificial intelligence program, including large language and generative AI models, without permission from the Academy.
Various terms have been used to describe the severity of retinopathy associated with central retinal venous obstruction. None is completely satisfactory. The clinical terms used to describe the ocular fundus reflect the degree of obstruction of the entire venous outflow from the retina (central retinal vein plus collateral vessels) and not just the central retinal vein alone. A patient may have complete anatomic obstruction of the central retinal vein at the level of the lamina cribrosa, with well-developed collateral venous channels, and manifest only minimal fundoscopic changes of venous occlusion.
Disease Entity
Definition
Retinal vein occlusion (RVO) is a common cause of vision loss in older individuals, and the second most common retinal vascular disease after diabetic retinopathy.[1] There are 2 distinct types, classified according to the site of occlusion: in central RVO (CRVO), the occlusion is at or proximal to the lamina cribrosa of the optic nerve, where the central retinal vein exits the eye.[2] CRVO is further divided into the categories of perfused (nonischemic) and nonperfused (ischemic), each of which has implications for prognosis and treatment.[3]
Pathophysiology
The pathogenesis of CRVO is believed to follow the principles of Virchow’s triad for thrombogenesis, involving vessel damage, stasis, and hypercoagulability.[4] The central retinal vein and artery share a common adventitial sheath at arteriovenous crossings posterior to the lamina cribrosa so that atherosclerotic changes of the artery may compress the vein and precipitate CRVO.[5] So, the pathogenesis of CRVO is related critically to the changes in the central retinal artery.
Damage to the retinal vessel wall from atherosclerosis and compression alters rheologic properties in the adjacent central vein, contributing to stasis, thrombosis, and, thus, occlusion.[6]
Risk Factors
Age
Age is the most important factor, since over 90% of cases occur in patients over the age of 55 years.
Hypertension
High blood pressure is present in up to 73% of CRVO patients over the age of 50 years and in 25% of younger patients. Inadequate control of hypertension may also predispose to recurrence of CRVO in the same or the fellow eye.
Hyperlipidemia
A total cholesterol level of >6.5 mmol/l is present in 35% of patients with CRVO, irrespective of age.
Diabetes mellitus
Hyperglycemia is present in about 10% of patients over the age of 50 years, but it is uncommon in younger patients. This may be due to an associated higher prevalence of other cardiovascular risk factors, such as hypertension, which is present in 70% of type 2 diabetics.
Oral contraceptive pill
In younger females, the contraceptive pill is the most common underlying association with CRVO, and it should not be taken following retinal vein occlusion. The risk may be exacerbated by thrombophilia.
Raised intraocular pressure
A high intraocular pressure (IOP) increases the risk of CRVO, particularly when the site of obstruction is at the edge of the optic cup.
Smoking
Current smoking may be associated with an increased incidence of CRVO, although studies have shown inconsistent results.
Other uncommon predispositions
Myeloproliferative disorders
- Polycythemia
- Abnormal plasma proteins (eg, myeloma, Waldenström macroglobulinemia)
Acquired hypercoagulable states
- Hyperhomocysteinemia
- Lupus anticoagulant and antiphospholipid antibodies
- Dysfibrinogenemia
Inherited hypercoagulable states
- Activated protein C resistance (factor V Leiden mutation)
- Protein C deficiency
- Protein S deficiency
- Antithrombin deficiency
- Prothrombin gene mutation
- Factor Xll deficiency
Inflammatory disease associated with occlusive periphlebitis
- Behçet syndrome
- Sarcoidosis
- Granulomatosis with polyangiitis (formerly Wegener)
- Goodpasture syndrome
Miscellaneous
- Chronic renal failure
- Causes of secondary hypertension (eg, Cushing syndrome) or hyperlipidemia (eg, hypothyroidism)
- Orbital disease
- Dehydration may be significant, particularly in younger patients and in hot countries
Diagnosis
Symptoms
Presentation is with sudden, unilateral blurred vision. In nonischemic CRVO, the blurring is mild and may be worse on waking, and it improves during the day. In ischemic CRVO, visual impairment is sudden and severe.[7] [8]
Clinical Diagnosis
Nonischemic CRVO (Perfused)
Nonischemic CRVO is the most common type, accounting for about 75%. Presentation is with sudden, unilateral blurred vision. The same clinical entity has also been called impending , incipient, partial, imminent, incomplete, or threatened CRVO.[3] Mild to moderate loss of acuity, usually 20/200 or better, and an absent or mild relative afferent pupillary defect (RAPD) characterize these patients. Fundoscopy shows tortuosity and dilatation of all branches of the central retinal vein, dot/blot and flame-shaped hemorrhages throughout all 4 quadrants and most numerous in the periphery, and optic disc and macular edema. Some cotton-wool spots, particularly in hypertensive patients, may be present. Transient retinal vessel wall sheathing may occur.[3][5]
The acute signs resolve over 6-12 months, with disc collaterals and pigmentary changes at the macula as residual findings. Conversion to ischemic CRVO occurs in 15% of cases within 4 months and 34% within 3 years. The patient should be instructed to make contact if the vision deteriorates, as this may indicate the development of significant ischemia or worsening macular edema. In cases that do not subsequently become ischemic, the prognosis is reasonably good, with return of vision to normal or near normal in about 50%.
Ischemic CRVO (Nonperfused)
Ischemic CRVO is characterized by rapid onset venous obstruction that results in decreased retinal perfusion, capillary closure, and retinal hypoxia. Patients with severe central retinal vein obstruction typically have severe visual loss, usually less than 20/200; a marked afferent pupillary defect; severe tortuosity and engorgement of all branches of the central retinal vein; extensive deep blot and flame-shaped hemorrhages involving the peripheral retina and posterior pole; and severe disc edema and hyperemia.
This may lead to profound vascular leakage, rubeosis iridis and raised intraocular pressure. The prognosis is extremely poor due to macular ischemia. Rubeosis iridis develops in about 50% of eyes, usually between 2 and 4 months (90-day glaucoma), and there is a high risk of neovascular glaucoma. Retinal neovascularization occurs in about 5% of eyes. Where possible, patients with ischemic CRVO should be seen monthly for 6 months to detect the onset of anterior segment neovascularization. Subsequent review should usually be for up to 2 years to detect significant ischemia and macular edema.[3][5]
Ischemic versus nonischemic CRVO
Hayreh and colleagues used the following initial criteria to define ischemic CRVO:
"for visual acuity, count fingers at only 1-2 ft or worse; for visual fields, ability to see only the V-4e target or worse; for RAPD, > 1.2 log units; for fluorescein fundus angiography, marked diffuse retinal capillary obliteration; and for ophthalmoscopy, extensive cotton-wool spots. (ERG was not used as one of the defining parameters)." However, after following the patients, they found that RAPD >0.7 log unit was more sensitive and specific.
The reliability of the tests for differentiation[9] was different. Most reliable was RAPD>ERG> perimetry> visual acuity> FFA (in acute phase may not provide satisfactory information)> Ophthalmoscopy. The combination of RAPD and ERG could almost differentiate all cases.
| Non-ischemic CRVO | Ischemic CRVO | |
|---|---|---|
| Visual acuity |
>20/200 |
<20/200 |
| RAPD (relative afferent papillary defect) |
Mild or absent |
Present (>0.7 log units of neutral density filter) |
| Visual field defect |
Rare |
Common (use of Goldmann perimeter is suggested, as 30 degree field misses peripheral changes) |
| Fundus appearance |
Less disc/macular edema, hemorrhage, cotton-wool spots Mild venous tortuosity and dilation |
More disc/macular edema, hemorrhage, cotton-wool spots Severe venous tortuosity and dilation |
| Fundus fluorescein angiogram |
Less area of nonperfusion |
Retinal capillary nonperfusion more than 10 disc areas |
| ERG/electroretinogram |
Normal |
Reduced b-wave amplitude (≤60% of the normal mean value of both photopic and scotopic ERG), and reduced b/a |
| Prognosis |
Good; less chance of anterior segment neovascularization/neovascular glaucoma |
Poor; high chance of anterior segment neovascularization/neovascular glaucoma The visual prognosis may be worse than central retinal arterial occlusion |
Imaging Studies
Fluorescein Angiography
In nonischemic CRVO, FA shows marked delay in arteriovenous transit time, which is longer than 20 seconds, masking by retinal hemorrhages, and vessel wall staining. Late staining along the large retinal veins is a characteristic finding in moderate and severe degrees of central retinal vein obstruction. The ischemic form has extensive areas of capillary nonperfusion. Greater than 10 disc areas of retinal capillary nonperfusion is associated with an increased risk of neovascularization.
A timed fluorescein angiographic study, preferably using a wide-angle fundus camera, can document the degree of obstruction, the severity of the capillary permeability alterations, and the extent of the retinal capillary nonperfusion especially after at least partial resolution of the intraretinal hemorrhages . It is important to include views of the peripheral fundus and the posterior pole, since capillary nonperfusion is most likely to occur in these areas. In the presence of widespread confluent hemorrhages, it may not be possible to determine angiographically the extent of capillary closure.
Optical Coherence Tomography
Optical coherence tomography (OCT) is useful in the assessment of macular edema, and particularly in monitoring its course, especially with treatment of the edema.
Typically, the OCT shows cystoid macular edema with or without subfoveal fluid. Epiretinal membrane or vitreomacular traction may also be evident.
In patients with recent-onset CRVO, OCT can detect areas of presumed ischemic edema in the plexiform layer due to ischemia of intermediary neurons within the inner nuclear and inner plexiform layers[10].
Fundus Autofluorescence
Fundus autofluorescence can detect a perivenular hypoautofluorescence with a fern-like appearance in patients with recent-onset CRVO.
This appearance is due to the masking of the normal autofluorescence from ischemic edema. In the retina, tissue transparency is a clinical index of tissue oxygenation. With CRVO, the most sensitive tissue for manifesting decreased oxygenation will be perivenular, and especially in the posterior pole, where oxygen use is higher than in the retinal periphery. The perivenular location of ischemic edema is due to decreased arterial flow that leads to preferential oxygenation of the periarterial retina, which uptakes the available oxygen and subsequently desaturates hemoglobin before it can reach the perivenular space. This will manifest as patchy ischemic retinal whitening, located preferentially in a perivenular distribution near the macula.[10]
Laboratory test
Consider the following testing, depending on clinical presentation:
All patients
- Blood pressure
- Erythrocyte sedimentation rate (ESR)
- Complete blood count (CBC)
- Random blood glucose
- Random total and HDL cholesterol
- Plasma protein electrophoresis (dysproteinemias such as multiple myeloma)
- Urea, electrolytes, and creatinine (renal disease in association with hypertension)
- Thyroid function tests (associated with dyslipidemia)
- ECG (left ventricular hypertrophy secondary to hypertension)
Additional tests in patients under age 50 with bilateral RVO, a history of previous thromboses, or a family history of thrombosis
- Chest X-ray (sarcoidosis, tuberculosis)
- C-reactive protein (CRP)
- "Thrombophilia screen" (thrombin time, prothrombin time and activated partial thromboplastin time, antithrombin functional assay, protein C, protein S, activated protein C resistance, factor V Leiden mutation, prothrombin G20210A mutation; anticardiolipin antibody, lupus anticoagulant)
- Autoantibodies (rheumatoid factor, anti-nuclear antibody, anti-DNA antibody)
- Serum angiotensin-converting enzyme (ACE)
- Fasting plasma homocysteine level
- Treponemal serology
- Carotid duplex imaging (exclude ocular ischemic syndrome)
Differential diagnosis
An important table on the differentiating features of CRVO, ocular ischemic syndrome, and diabetic retinopathy is available at https://eyewiki.aao.org/Ocular_Ischemic_Syndrome#Differential_diagnosis
Management
Follow-up
Follow-up of CRVO is tailored to fit the different entities and to prevent complications. In a clearly nonischemic CRVO without macular edema, initial follow-up should take place after 4-6 weeks to monitor for development of edema or worsening ischemia. The patient should be instructed to make contact if the vision deteriorates, as this may indicate the development of significant edema and/or ischemia. Subsequent follow-ups are dependent on the clinical picture.
If macular edema is present, anti-VEGF therapy is the current first-line treatment. In the beginning, monthly follow-up is needed with OCT for monitoring treatment response and continued therapy to minimize the macular edema. Over time, the injection intervals may be adjusted, depending on treatment response.
Where possible, patients with ischemic CRVO should be seen monthly for 6 months to detect the onset of anterior segment neovascularization. The risk is highest within the first 90 days for development of rubeosis, as per the CVOS. The risk remains elevated through 6 months. Routine gonioscopy of eyes at risk should therefore be performed, and the pupillary margin should be examined prior to mydriasis. In the era of anti-VEGF therapy, it is important to monitor these ischemic eyes closely when discontinuing injections as the risk of neovascularization may have been mitigated by the anti-VEGF medication.
General treatment
There is no convincing evidence that medical treatment favorably alters the natural course of the central retinal vein occlusion itself. Pilot studies have suggested that oral inhibitor of platelet and erythrocyte aggregation, and hemodilution treatment to lower blood viscosity, may be of some benefit. Intravenous administration of streptokinase appeared to reduce the morbidity but has never gained favor, due to the risk of vitreous hemorrhage.
Complications
The hypoxic retinal tissue in CRVO releases vascular endothelial growth factor (VEGF) and inflammatory mediators, thereby inducing the complications of macular edema, vitreous hemorrhage, and neovascular glaucoma.
Macular Edema
Currently, the first-line treatment for macular edema due to CRVO is anti-VEGF therapy with intravitreal bevacizumab, ranibizumab, aflibercept, or faricimab. Second-line treatments typically include intravitreal triamcinolone and dexamethasone implant.
Specific details of various treatments may be found below:
Macular Grid Laser
Macular grid laser is not recommended, since it may reduce angiographically the macular leakage, but without benefit on the visual acuity. The CVOS showed no benefit in terms of visual acuity in older patients, although a trend toward better acuity was seen in younger patients.[11]
Intravitreal Therapy
Standard Care Versus Corticosteroid for Retinal Vein Occlusion (SCORE)
Between November 2004 and February 2008, 271 patients with CRVO were enrolled in the SCORE study, which was designed to compare 1 mg and 4 mg IVTA with standard-care treatment for vision loss associated with macular edema secondary to RVO. In patients with CRVO (the SCORE–CRVO trial), standard care was observation. In the SCORE–CRVO trial, the primary outcome — that is, the percentage of participants with a gain in visual acuity letter score of 15 or more from baseline to month 12 — was 6.8%, 26.5%, and 25.6% for the observation, 1-mg, and 4-mg groups, respectively. In contrast to the visual acuity results, there was no difference in retinal thickness between groups at 12 months.[12] With respect to optical coherence tomography (OCT)- measured central retinal thickness (CRT), all 3 groups showed a decrease from baseline to month 12. Analogous to the visual acuity results, only at month 4 did the 4-mg triamcinolone group demonstrate a greater treatment effect on center-point thickness than the 1-mg and standard-care groups. The rate of adverse events was higher in the 4-mg triamcinolone group. There was a dose-dependent higher frequency of initiating IOP-lowering medications in the triamcinolone groups (41% in the 4-mg group and 7% in the 1-mg group) compared with the standard-care group (2%). The proportion of eyes that were phakic at baseline and had new-onset lens opacity or progression of an existing opacity through 12 months was greater in the 2 triamcinolone groups (25%–35%)[13] [14] [15]
Summary: intravitreal triamcinolone 1 mg appears to be effective for the treatment of macular edema and safer than the 4 mg dose.
Ranibizumab for the Treatment of Macular Edema After Central Retinal Vein OcclUsIon Study (CRUISE)
Between July 2007 and December 2008, 392 patients diagnosed with CRVO were randomized to monthly intraocular injections of 0.3 mg or 0.5 mg ranibizumab, or sham injections, for 6 months, with a further 6 months' follow-up. Mean study eye baseline best-corrected visual acuity (BCVA) was 20/100, and mean baseline CRT was 685.2 μm. The primary efficacy outcome was mean change from baseline BCVA at 6 months; at month 6, patients in the 0.3- and 0.5-mg ranibizumab treatment groups had gained a mean of 12.7 and 14.9 letters, respectively, compared with 0.8 letters in the sham group. The improvement in BCVA letter score after injection of ranibizumab was rapid, with patients having gained an average of 9 letters 7 days after the first injection. Among the secondary outcomes, at month 6, 46.2% and 47.7% of patients in the 0.3- and 0.5-mg ranibizumab groups, respectively, had gained ≥15 letters from baseline BCVA, compared with 16.9% of patients in the sham group. Concomitant with the rapid improvement in BCVA, there was a rapid reduction in central foveal thickness after treatment with ranibizumab: at day 7, the mean reduction from baseline CRT was >250 μm in both ranibizumab groups, compared with no reduction in the sham group. There were no events of endophthalmitis, retinal tear, or retinal detachment during the 6-month treatment period.[16][17] [18]
Summary: Intravitreal ranibizumab 0.5 mg is currently FDA-approved for the treatment of macular edema due to retinal vein occlusion.
Ozurdex GENEVA study group
Dexamethasone is a potent, water-soluble corticosteroid that can be delivered to the vitreous cavity by the dexamethasone intravitreal implant (DEX implant; Ozurdex). A DEX implant is composed of a biodegradable copolymer of lactic acid and glycolic acid-containing micronized dexamethasone.
The drug–copolymer complex gradually releases the total dose of dexamethasone over a series of months after insertion into the eye through a small pars plana puncture, using a customized applicator system.
A total of 1267 patients (DEX implant 0.7 mg: n = 427; DEX implant 0.35 mg: n = 414; sham: n = 426) were recruited into the study between November 2004 and March 2008. At baseline, mean visual acuity was approximately 20/80 in all groups, and mean CRT was approximately 550 μm. Eyes receiving DEX implant 0.7 or 0.35 mg achieved a 15-letter improvement in BCVA significantly faster than the eyes receiving sham treatment; furthermore, the response rates in the DEX implant 0.7-mg group were often numerically higher than those in the DEX implant 0.35-mg group. The greater improvements in visual acuity with the DEX implant were accompanied by a greater decrease in OCT-measured CRT than were seen with sham treatment.
The improvements in visual acuity outcomes persisted longer than the reduction in retinal thickness as measured by OCT, which suggests that factors in addition to changes in CRT may be affecting visual acuity in RVO eyes treated with the DEX implant. The adverse events that occurred at a significantly higher rate in the DEX implant treatment group than in the sham group were eye pain, ocular hypertension, and anterior chamber cells; there was no statistically significant difference in the rate of cataract among the treatment groups, but 180 days may not be a long enough study period to detect an effect of treatment on cataract formation. The majority of patients treated with DEX implant did not experience a substantial increase in IOP; at peak (day 60), less than 16% of all eyes had an increase in IOP to ≥25 mm Hg. Increase in IOP was typically transient, and nearly all cases of elevated IOP were managed with observation or topical medications alone.[19][20]
Summary: Intravitreal dexamethasone implant is currently FDA-approved for the treatment of macular edema due to retinal vein occlusion.
Aflibercept for the Treatment of Macular Edema after Central Retinal Vein Occlusion (COPERNICUS/GALILEO)
Patients diagnosed with CRVO in the Controlled Phase 3 Evaluation of Repeated Intravitreal Administration of VEGF Trap-Eye in Central Retinal Vein Occlusion: Utility and Safety (COPERNICUS) and the almost identical General Assessment Limiting Infiltration of Exudates in Central Retinal Vein Occlusion with VEGF Trap-Eye (GALILEO) studies received 6-monthly injections of either VEGF Trap-Eye (aflibercept) at a dose of 2 mg or sham injections. Patients in both trials were randomized in a 3:2 ratio, with 114 patients randomized to receive aflibercept and 73 randomized to the control arm in COPERNICUS, and 104 patients randomized to receive aflibercept and 68 randomized to the control arm in GALILEO. At the end of the initial 6 months, all patients randomized to aflibercept were dosed on a pro re nata (as needed) basis for another 6 months. In the COPERNICUS trial, patients randomized to sham injections in the first 6 months were eligible to cross over to aflibercept pro re nata dosing in the second 6 months. During the second 6 months of the studies, all patients were eligible for rescue laser treatment. In the COPERNICUS trial, 56.1% of patients receiving aflibercept 2 mg monthly gained at least 15 letters of vision from baseline, compared with 12.3% of patients receiving sham injections. In the GALILEO study, 60.2% of patients receiving aflibercept 2 mg monthly gained at least 15 letters of vision from baseline, compared with 22.1% of patients receiving sham injections, the primary end point of the study. Patients receiving aflibercept 2 mg monthly gained, on average, 18 letters of vision, compared with a mean gain of 3.3 letters with sham injections, a secondary end point. Aflibercept was generally well tolerated, and the most common adverse events were those typically associated with intravitreal injections; serious ocular adverse events in the aflibercept group were uncommon (3.5%) and were more frequent in the control group (13.5%). The incidence of nonocular adverse events was generally well balanced between the treatment arms.
Summary: intravitreal aflibercept is currently FDA-approved for the treatment of macular edema due to retinal vein occlusion.
Study of Comparative Treatments for Retinal Vein Occlusion 2 (SCORE2) Trial
Between September 2014 and November 2015, 362 patients were enrolled at 66 private practice or academic centers within the United States to study the effect of bevacizumab versus aflibercept on visual acuity among patients with macular edema due to CRVO or HCRVO. The SCORE2 was a randomized noninferiority study where patients were randomized 1:1 to receive intravitreal injections of either bevacizumab (1.25 mg) or aflibercept (2.0 mg) every 4 weeks through month 6. The primary outcome was mean change in visual acuity letter score (VALS) from baseline to month 6 with a noninferiority margin of 5 letters. At month 6, there was a mean visual letter score increase from baseline of 18.9 letters in the aflibercept group compared to 18.6 letters in the bevacizumab group, meeting the criteria for noninferiority. In the aflibercept group, 114 eyes (65.1%) had achieved the secondary outcome of a gain of at least 15 letters compared with 106 eyes (61.3%) in the bevacizumab group at month 6. Less than 2% in each group had a >15-letter loss at month 6. Both groups showed statistically significant SD-OCT central subfield thickness decrease from baseline, with a mean decrease of 425 μm at month 6 in the aflibercept group, compared to 387 μm in the bevacizumab group. There was a significant difference in rate of complete resolution of macular edema with 54% of aflibercept eyes, compared to 29% in the bevacizumab group achieving complete resolution of edema. Adverse events in both groups included elevated intraocular pressure with a report of endophthalmitis (culture negative) in the bevacizumab group. [21] [22]
In addition, SCORE2 compared monthly dosing to treat-and-extend (TAE) dosing of aflibercept or bevacizumab from 6 to 12 months, with respect to visual acuity and central retinal thickness at month 12 in participants who had a protocol-defined good response after 6 monthly injections of aflibercept or bevacizumab. TAE dosing resulted in an average of 1 to 2 fewer injections over 6 months than monthly dosing. Meaningful visual acuity differences at 12 months were not observed between TAE and monthly schedules. However, because of the widths of the confidence intervals on the visual acuity differences between the monthly and TAE arms, the study could not conclude that the 2 dosing regimens were associated with similar vision outcomes.[23]
SCORE2 also evaluated the impact of switching to either a different anti-VEGF agent or to intravitreal dexamethasone in eyes that did not have a protocol-defined good response after 6 monthly injections of aflibercept or bevacizumab. Eyes receiving monthly aflibercept were switched to a dexamethasone implant and eyes receiving monthly bevacizumab were switched to monthly aflibercept initially and then to a TAE regimen. A total of 49 eyes were studied. Eyes treated with aflibercept after a poor response to bevacizumab had improvement in VA and CST. Fewer eyes (14/49) had a poor initial response to aflibercept and thus were switched to dexamethasone. The study was unable to conclude that the switching strategy was superior to maintaining treatment due to the small number of eyes and lack of comparison groups.[24]
Faricimab for the Treatment of Macular Edema after Central Retinal Vein Occlusion (COMINO)
Faricimab is a humanized, bispecific, immunoglobulin G monoclonal antibody designed for intravitreal injection that binds and neutralizes both angiopoietic-2 and VEGF-A. Angiopoietin-2 levels have been found to be elevated in patients with RVO. This factor disrupts vascular stability and may play a key role in cytokine-induced vascular leakage. COMINO was a phase 3 double-masked, clinical trial that randomized treatment-naive eyes with focal center-involved macular edema due to CRVO 1:1 to faricimab 6 mg or aflibercept 2 mg every 4 weeks for 24 weeks.[25] The primary endpoint was change in BCVA from baseline to week 24. A total of 729 patients were enrolled. The study met its primary endpoint with noninferior adjusted mean BCVA gains with faricimab vs. aflibercept (+16.9 letters vs. +17.3 letters). Adjusted mean central subfield thickness reductions from baseline were comparable for faricimab and aflibercept at week 24 (-461.6 μm vs. -448.8 μm). A greater proportion of patients in the faricimab arm achieved absence of fluorescein angiography-based macular leakage at week 24 compared to aflibercept (44.4% vs. 30.0%; nominal p=0.0002). The incidence of ocular adverse events was similar between faricimab and aflibercept (23% vs 27.7%).
Summary: intravitreal faricimab is currently FDA-approved for the treatment of macular edema due to retinal vein occlusion.
Neovascularization
It has been fully established in the CVOS study that there is no apparent benefit in performing panretinal photocoagulation (PRP) before development of iris and angle neovascularization, provided that frequent follow-up examinations can be performed, since prophylactic treatment does not totally prevent iris and angle neovascularization. Furthermore, regression of iris and angle neovascularization in response to PRP is more likely to occur in eyes that have not been treated previously. Prompt laser PRP (1500–3000 burns, 0.5–0.1 second, spaced one burn width apart) should be performed in eyes in which iris and angle neovascularization develops. Some cases require further treatment if rubeosis fails to regress or continues to progress. Intravitreal anti-VEGF injections may be used adjunctively in selected cases. It is important to screen patients monthly for the development of iris or angle neovascularization, as discussed above, based on the results from the CVOS.
Vitreous Hemorrhage
Vitreous hemorrhage can lead to sudden vision deterioration and can hinder PRP. There has not been a standard treatment until recently for CRVO with vitreous hemorrhage. Currently, for unresolved vitreous hemorrhage, pars plana vitrectomy performed concurrently with intraoperative PRP is the management strategy. The benefits of vitrectomy for vitreous hemorrhage secondary to CRVO are obvious. First, it removes the opaque hemorrhage and clears the visual axis, which can improve vision. Second, PRP can be performed completely during surgery. Furthermore, studies have indicated that vitrectomy elevates oxygen tension for many months, relatively decreasing the ischemic situation after CRVO and preventing neovascular glaucoma. There is little information about the influence of anti-VEGF treatment on vitreous hemorrhage secondary to CRVO. Theoretically, anti-VEGF could play a role in the treatment of CRVO with vitreous hemorrhage, because this disease shares a similar pathogenesis to diseases such as vitreous hemorrhage secondary to proliferative diabetic retinopathy.
Prognosis
In cases that do not subsequently become ischemic, the prognosis is reasonably good, with return of vision to normal or near normal in about 50%. The main cause for poor vision is chronic macular edema, which may lead to secondary RPE changes. To a certain extent, the prognosis is related to initial visual acuity as follows:
- 20/60 or better, it is likely to remain so
- 20/80-20/200, the clinical course is variable, and vision may subsequently improve, remain the same, or worsen
- Worse than 20/200, improvement is unlikely
The prognosis of ischemic CRVO is extremely poor due to macular ischemia. Rubeosis iridis develops in about 50% of eyes, usually between 2 and 4 months (100-day glaucoma), and there is a high risk of neovascular glaucoma. The development of optociliary shunts may protect the eye from anterior segment neovascularization and probably indicates a dramatic reduction in risk. Retinal neovascularization occurs in about 5% of eyes.
Additional Resources
- Gregori NZ, Vemulakonda GA. Central Retinal Vein Occlusion. American Academy of Ophthalmology. EyeSmart/Eye health. https://www.aao.org/eye-health/diseases/central-retinal-vein-occlusion-list. Accessed January 06, 2023.
- Porter D, Vemulakonda GA. Blood Pressure. American Academy of Ophthalmology. EyeSmart/Eye health. https://www.aao.org/eye-health/anatomy/blood-pressure-list. Accessed January 06, 2023.
References
- ↑ Cugati S, Wang JJ. Retinal vein occlusion and vascular mortality: pooled data analysis of 2 population-based cohorts. Ophthalmology 114, 520–524.
- ↑ Mitchell P, Smith W, Chang A. Prevalence and associations of retinal vein occlusion in Australia. The Blue Mountains Eye Study. Arch Ophthalmol. 114, 1243–1247.
- ↑ 3.0 3.1 3.2 3.3 Hayreh SS. Classification of central retinal vein occlusion. Ophthalmology. 90(5), 458–474.
- ↑ Rogers S, McIntosh RL, Cheung N et al. The prevalence of retinal vein occlusion: pooled data from population studies from the United States, Europe, Asia, and Australia. Ophthalmology. 117(2), 313.e1–319.e1.
- ↑ 5.0 5.1 5.2 Parodi MB, Bandello F. Retinal vein occlusion: classification and treatment. Ophthalmologica. 223(5), 298–305.
- ↑ Rehak J, Rehak M. Retinal vein occlusion: pathogenesis, visual prognosis, and treatment modalities. Curr Eye Res. 33(2), 111–131.
- ↑ McIntosh RL, Rogers SL, Lim L et al. Natural history of central retinal vein occlusion: an evidence-based systematic review. Ophthalmology. 117(6), 1113.e15–1123.e15.
- ↑ Decroos FC, Fekrat S. The natural history of retinal vein occlusion: what do we really know? Am J Ophthalmol. 151(5), 739–741.e2.
- ↑ Hayreh SS, Klugman MR, Beri M, Kimura AE, Podhajsky P. Differentiation of ischemic from non-ischemic central retinal vein occlusion during the early acute phase. Graefes Arch Clin Exp Ophthalmol. 1990;228(3):201-17. PubMed PMID: 2361592.
- ↑ 10.0 10.1 Pichi F, Morara M, Veronese C, Lembo A, Nucci P, Ciardella AP. Perivenular whitening in central vein occlusion described by fundus autofluorescence and spectral domain optical coherence tomography. Retina. 2012 Jul;32(7):1438-9.
- ↑ AP Ciardella, M Morara, F Pichi, M Alkabes, S Romano, P Nucci. Management of macular edema secondary to retinal vein occlusions. Expert Review of Ophthalmology. 6 (5), 557-564
- ↑ Gewaily D, Greenberg PB. Intravitreal steroids versus observation for macular edema secondary to central retinal vein occlusion. Cochrane Database Syst. Rev. 1, CD007324.
- ↑ The SCORE study research group. A randomized trial comparing the efficacy and safety of intravitreal triamcinolone with observation to treat vision loss associated with macular edema secondary to central retinal vein occlusion. The Standard Care vs Corticosteroid for Retinal Vein Occlusion (SCORE) Study Report 5. Arch Ophthalmol. 127, 1101–1114.
- ↑ The SCORE Study Research Group. A randomized trial comparing the efficacy and safety of intravitreal triamcinolone with observation to treat vision loss associated with macular edema secondary to branch retinal vein occlusion. The Standard Care vs Corticosteroid for Retinal Vein Occlusion (SCORE) Study Report 6. Arch Ophthalmol. 127, 1115–1128.
- ↑ Ip MS, Oden NL, Scott IU et al. SCORE Study Investigator Group. SCORE Study report 3: study design and baseline characteristics. Ophthalmology. 116, 1770–1777.
- ↑ Campochiaro PA, Hafiz G, Shah SM et al Ranibizumab for macular edema due to retinal vein occlusions: implication of VEGF as a critical stimulator. Mol Ther. 16, 791–799.
- ↑ Brown DM, Campochiaro PA, Singh RP et al. Ranibizumab for macular edema following central retinal vein occlusion: six-month primary end point results of a Phase III study. Ophthalmology. 117, 1124–1233.
- ↑ Brown DM, Campochiaro PA, Singh RP et al.; CRUISE Investigators. Ranibizumab for macular edema following central retinal vein occlusion: six-month primary end point results of a phase III study. Ophthalmology. 117(6), 1124–1133.e1.
- ↑ Haller JA, Bandello F, Belfort R et al. Randomized, sham controlled trial of dexamethasone intravitreal implant in patients with macular edema due to retinal vein occlusion. Ophthalmology. 117, 1134–1146.
- ↑ Haller JA, Bandello F, Belfort R Jr et al.; Ozurdex GENEVA Study Group. Dexamethasone Intravitreal Implant in Patients with Macular Edema Related to Branch or Central Retinal Vein Occlusion Twelve-Month Study Results. Ophthalmology. DOI: 10.1016/j ophtha.2011.05.014.
- ↑ Scott IU, VanVeldhuisen PC, Ip MS, et al, for the SCORE2 Investigator Group. Effect of bevacizumab vs aflibercept on visual acuity among patients with macular edema due to central retinal vein occlusion. The SCORE2 randomized clinical trial. JAMA. 2017:317:2072-2087.
- ↑ Scott IU, VanVeldhuisen PC, Ip MS, et al, for the SCORE2 Investigator Group. SCORE2 Study Report 4. Baseline factors associated with 6-month visual acuity and retinal thickness outcomes in patients with macular edema secondary to central retinal vein occlusion or hemiretinal vein occlusion. JAMA Ophthalmol. 2017;135:639-649
- ↑ Scott IU, VanVeldhuisen PC, Ip MS, Blodi BA, Oden NL, Altaweel M, Berinstein DM; SCORE2 Investigator Group. Comparison of Monthly vs Treat-and-Extend Regimens for Individuals With Macular Edema Who Respond Well to Anti-Vascular Endothelial Growth Factor Medications: Secondary Outcomes From the SCORE2 Randomized Clinical Trial. JAMA Ophthalmol. 2018 Apr 1;136(4):337-345. doi: 10.1001/jamaophthalmol.2017.6843.
- ↑ Ip MS, Oden NL, Scott IU, VanVeldhuisen PC, Blodi BA, Ghuman T, Baker CW; SCORE2 Investigator Group. Month 12 Outcomes After Treatment Change at Month 6 Among Poor Responders to Aflibercept or Bevacizumab in Eyes With Macular Edema Secondary to Central or Hemiretinal Vein Occlusion: A Secondary Analysis of the SCORE2 Study. JAMA Ophthalmol. 2019 Mar 1;137(3):281-287. doi: 10.1001/jamaophthalmol.2018.6111.
- ↑ Tadayoni R, Paris LP, Danzig CJ, Abreu F, Khanani AM, Brittain C, Lai TYY, Haskova Z, Sakamoto T, Kotecha A, Schlottmann PG, Liu Y, Seres A, Retiere AC, Willis JR, Yoon YH; BALATON and COMINO Investigators. Efficacy and Safety of Faricimab for Macular Edema due to Retinal Vein Occlusion: 24-Week Results from the BALATON and COMINO Trials. Ophthalmology. 2024 Jan 26:S0161-6420(24)00090-3. doi: 10.1016/j.ophtha.2024.01.029. Epub ahead of print. PMID: 38280653.